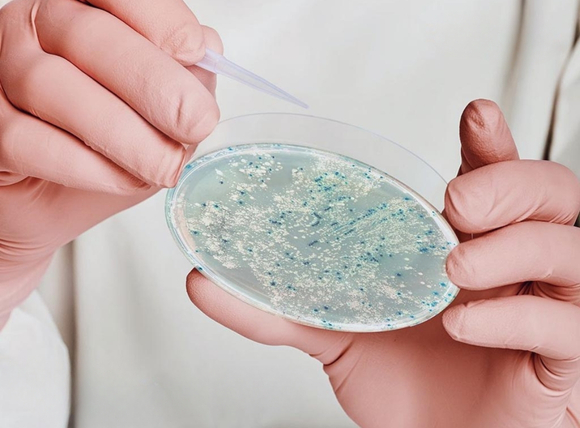
Phương pháp kiểm tra chính xác nước giếng nhiễm E.coli

Nước giếng nhiễm E.coli: Sử dụng UV, Ozone hay Chlorine là câu hỏi quan trọng khi nguồn nước giếng khoan của gia đình bạn có nguy cơ bị nhiễm vi khuẩn E.coli từ bể phốt, khu chăn nuôi hoặc nước thải ngấm xuống.
Ba phương pháp UV, Ozone và Chlorine đều có khả năng diệt khuẩn hiệu quả nhưng khác nhau về cơ chế hoạt động, chi phí đầu tư và điều kiện ứng dụng.
Khi đứng trước quyết định nước giếng nhiễm E.coli: Sử dụng UV, Ozone hay Chlorine, nhiều gia đình băn khoăn không biết phương pháp nào an toàn, hiệu quả và tiết kiệm nhất.
UV không dùng hóa chất nhưng yêu cầu nước phải trong, Chlorine rẻ tiền nhưng tạo sản phẩm phụ THMs có hại, còn Ozone mạnh mẽ nhưng chi phí cao và hệ thống phức tạp.
Việc hiểu rõ ưu nhược điểm, cơ chế diệt khuẩn và điều kiện vận hành của từng công nghệ sẽ giúp bạn đưa ra lựa chọn đúng đắn cho nguồn nước sinh hoạt an toàn.

I. Cách nhận biết nước giếng khoan bị nhiễm vi khuẩn E.coli
Việc phát hiện sớm dấu hiệu nhiễm vi khuẩn Escherichia coli trong nguồn nước giếng khoan giúp hộ gia đình có biện pháp xử lý kịp thời, tránh các bệnh lý tiêu hóa nguy hiểm. Vi khuẩn đường ruột này xuất hiện trong nước chứng tỏ đã có sự xâm nhập của phân người hoặc gia súc vào tầng chứa nước ngầm.
1.1. Dấu hiệu cảm quan của nước nhiễm E.coli
Quan sát bằng giác quan là bước đầu tiên giúp nhận diện vấn đề chất lượng nước, tuy nhiên cần lưu ý rằng không phải lúc nào nước nhiễm khuẩn cũng có biểu hiện rõ ràng.
—> Nội dung quan trọng cần biết: [E.coli trong nước giếng gây ra 5 bệnh cực nguy hiểm].
Các dấu hiệu thường gặp:
- Mùi bất thường: Nước phát ra mùi hôi tanh, mùi lạ đặc biệt sau những cơn mưa lớn hoặc khi bể chứa không được vệ sinh trong thời gian dài
- Độ đục thay đổi: Nước có màu vàng nhạt, xám hoặc xuất hiện các hạt cặn lơ lửng khi để yên trong bình thủy tinh
- Vị khác lạ: Nước có vị tanh, đắng hoặc để lại cảm giác khó chịu khi nuốt

Lưu ý quan trọng: Vi sinh vật E.coli có kích thước cực nhỏ (khoảng 0.5 - 3 micromet), mắt thường không thể phát hiện. Nước trong vắt vẫn có thể chứa hàng triệu khuẩn lạc gây bệnh. Do đó, dấu hiệu cảm quan chỉ mang tính chất tham khảo, không thể thay thế phương pháp xét nghiệm vi sinh chuyên môn.
1.2. Phương pháp kiểm tra chính xác nước giếng nhiễm E.coli
Xét nghiệm vi sinh học là cách duy nhất xác định chính xác nồng độ vi khuẩn Coliform và E.coli trong mẫu nước. Quy trình kiểm tra tuân theo tiêu chuẩn QCVN 01:2009/BYT về chất lượng nước ăn uống.
Quy trình lấy mẫu chuẩn:
- Chuẩn bị: Sử dụng chai thủy tinh hoặc nhựa vô trùng dung tích 500ml - 1 lít
- Lấy mẫu: Mở vòi nước chảy mạnh trong 2-3 phút, sau đó giảm dòng chảy và lấy mẫu trực tiếp vào chai
- Bảo quản: Đậy nắp kín, giữ lạnh 4-8°C, vận chuyển đến phòng xét nghiệm trong vòng 6 giờ
- Tần suất: Kiểm tra định kỳ 3-6 tháng/lần, hoặc ngay khi phát hiện dấu hiệu bất thường
—> Có thể bạn quan tâm: [Nước nhiễm mangan: Nguyên nhân, dấu hiệu và cách xử lý].
Kỹ thuật phân tích phổ biến:
- Phương pháp lọc màng (Membrane Filtration): Nước được lọc qua màng cellulose có kích thước lỗ 0.45 micromet, sau đó nuôi cấy trên môi trường m-Endo agar hoặc m-FC agar ở nhiệt độ 35-37°C trong 18-24 giờ
- Phương pháp ống nghiệm đa ống (Multiple Tube Fermentation): Sử dụng môi trường Lactose Broth, quan sát sự hình thành khí và đục để xác định số MPN (Most Probable Number)
- Kỹ thuật enzyme: Sử dụng môi trường chứa chất nền 4-methylumbelliferyl-β-D-glucuronide phát hiện hoạt tính enzyme β-glucuronidase đặc trưng của E.coli
—> Có thể bạn quan tâm: [Nước nhiễm Asen: Nguyên nhân, nhận biết và cách xử lý tốt nhất].
Tiêu chuẩn an toàn: Theo QCVN 01:2009/BYT, nước uống phải có Tổng Coliform = 0 CFU/100ml và E.coli = 0 CFU/100ml. Nồng độ vượt quá 100 CFU/100ml cần xử lý ngay lập tức.
1.3. Nguy cơ giếng khoan bị nhiễm E.coli cao
Vị trí địa lý và cấu trúc công trình giếng quyết định trực tiếp khả năng xâm nhập của vi khuẩn từ bên ngoài vào tầng nước ngầm.
Các yếu tố làm tăng nguy cơ nhiễm khuẩn:
|
Yếu tố
|
Mức độ nguy hiểm
|
Khoảng cách an toàn
|
|
Bể phốt, bể tự hoại
|
Rất cao
|
Tối thiểu 15-20m
|
|
Chuồng trại chăn nuôi
|
Cao
|
Tối thiểu 20-30m
|
|
Ao biogas, hầm ủ phân
|
Cao
|
Tối thiểu 15-25m
|
|
Kênh mương thoát nước thải
|
Trung bình
|
Tối thiểu 10-15m
|
|
Vùng trũng, thường xuyên ngập úng
|
Trung bình
|
Nên tránh hoàn toàn
|
Đặc điểm công trình dễ bị nhiễm:
- Giếng nông (độ sâu < 15m): Tầng chứa nước gần mặt đất, dễ bị thấm nhiễm từ nguồn ô nhiễm bề mặt
- Không có tường bao bảo vệ: Nước mưa chảy tràn mang theo vi khuẩn, phân động vật, chất thải hữu cơ
- Nắp đậy hở hoặc không kín: Côn trùng, chuột, bụi bẩn rơi trực tiếp vào giếng
- Vỏ ống bị nứt, rạn: Nước thải thấm vào qua các khe hở trong kết cấu bê tông hoặc ống nhựa PVC
- Kết cấu đầu giếng thấp: Nước mặt đọng tràn vào khi mưa lớn hoặc lũ lụt
—> Có thể bạn quan tâm: [Nước nhiễm chì: Nguyên nhân, tác hại, nhận biết và cách xử lý].

Chu kỳ kiểm tra khuyến nghị:
- Giếng gần nguồn ô nhiễm (< 15m): Kiểm tra 2-3 tháng/lần
- Giếng vùng an toàn: Kiểm tra 6 tháng/lần
- Sau sự cố (lũ lụt, động vật chết rơi vào giếng): Kiểm tra ngay lập tức
II. Xử lý nước nhiễm E.coli bằng Chlorine
Phương pháp khử trùng hóa học sử dụng Clo là giải pháp được ứng dụng rộng rãi nhất trên thế giới trong xử lý nước sinh hoạt và nước uống. Chi phí thấp, dễ triển khai và hiệu quả diệt khuẩn cao là những lý do chính khiến Chlorine trở thành lựa chọn hàng đầu cho các hệ thống cấp nước quy mô lớn và hộ gia đình.
2.1. Cơ chế diệt khuẩn E.coli của Chlorine
Quá trình tiêu diệt vi sinh vật của Clo dựa trên phản ứng oxy hóa khử mạnh mẽ, phá hủy cấu trúc tế bào và vật chất di truyền của vi khuẩn. Chuỗi phản ứng hóa học:
Khi hòa tan vào nước, Chlorine trải qua các giai đoạn phản ứng:
- Thủy phân: Cl₂ + H₂O → HOCl + HCl
- Ion hóa: HOCl ⇌ H⁺ + OCl⁻
- Tấn công tế bào: HOCl (axit hypochlorous) là dạng hoạt tính mạnh nhất, có khả năng xuyên qua màng tế bào vi khuẩn
- Oxy hóa nội bào: Phá hủy enzyme, protein, lipid màng, DNA của E.coli
—> Có thể bạn quan tâm: [Nước nhiễm kim loại nặng: Nguyên nhân, tác hại và cách xử lý].

Yếu tố ảnh hưởng hiệu quả:
- Độ pH: Tối ưu ở pH 6.5-7.5. Khi pH > 8, HOCl chuyển thành OCl⁻ kém hoạt tính, cần tăng liều lượng gấp 1.5-2 lần
- Nhiệt độ: Tăng 10°C làm tăng tốc độ phản ứng gấp đôi
- Nồng độ Clo tự do: Duy trì 0.5-1.0 mg/L trong quá trình tiếp xúc, sau đó giảm xuống 0.2-0.5 mg/L dư lượng bảo vệ
- Thời gian tiếp xúc (CT value): Tối thiểu 30 phút ở nhiệt độ 20°C để đạt mức diệt 99.99% E.coli
2.2. Ưu điểm của phương pháp Chlorine khử trùng
Công nghệ Clo hóa nước mang lại nhiều lợi ích về mặt kỹ thuật và kinh tế, đặc biệt phù hợp với điều kiện Việt Nam.
Ưu thế nổi bật:
- Chi phí đầu tư thấp: Bơm định lượng và bình chứa hóa chất có giá thành từ 3-8 triệu đồng, phù hợp ngân sách hộ gia đình
- Dễ mua, sẵn có: Hóa chất Clo (dạng viên, lỏng, bột) bán rộng rãi tại cửa hàng vật liệu xây dựng, đại lý hóa chất
- Khả năng khử trùng dư: Nồng độ Clo tồn tại trong đường ống tiếp tục tiêu diệt vi khuẩn xâm nhập từ các mối nối, khe hở
- Dễ đo lường, kiểm soát: Bộ test kit Clo giá 200-500 nghìn đồng cho phép kiểm tra nhanh tại nhà
- Hiệu quả diệt đa dạng vi sinh: Ngoài E.coli, Chlorine còn tiêu diệt Salmonella, Shigella, virus Hepatitis A, nấm mốc, tảo

—> Có thể bạn quan tâm: [Nước nhiễm phèn? Nguyên nhân, tác hại, cách lọc nước phèn].
Ứng dụng thực tế:
- Khử trùng toàn bộ hệ thống giếng khoan mới khoan hoặc sau sửa chữa
- Xử lý nước sinh hoạt cho hộ gia đình, trường học, bệnh viện
- Hệ thống cấp nước tập trung cho khu dân cư, khu công nghiệp
- Khử trùng nước bể bơi, nước rửa rau củ trong nhà hàng, bếp ăn công nghiệp
2.3. Nhược điểm và nguy cơ độc hại của Chlorine
Bên cạnh ưu điểm vượt trội, việc sử dụng Clo cần thận trọng do các tác động tiêu cực đến sức khỏe và chất lượng nước. Sản phẩm phụ gây hại (DBPs - Disinfection By-Products). Khi Chlorine phản ứng với chất hữu cơ tự nhiên (NOM), axít humic, fulvic trong nước, hình thành các hợp chất nguy hiểm:
|
Nhóm chất
|
Tên hóa chất
|
Nguy cơ sức khỏe
|
Nồng độ giới hạn
|
|
THMs
|
Chloroform (CHCl₃)
|
Gây ung thư gan, thận
|
< 80 µg/L (EPA)
|
|
THMs
|
Bromodichloromethane
|
Gây độc thần kinh
|
< 80 µg/L
|
|
HAAs
|
Dichloroacetic acid
|
Tổn thương gan
|
< 60 µg/L
|
|
HAAs
|
Trichloroacetic acid
|
Rối loạn sinh sản
|
< 60 µg/L
|
Tác động tiêu cực khác:
- Mùi vị khó chịu: Dư lượng Clo > 0.5 mg/L tạo mùi hăng, vị đắng làm giảm cảm quan nước uống
- Phá hủy vi khuẩn có ích: Diệt cả vi sinh vật đường ruột cần thiết cho tiêu hóa
- Ăn mòn kim loại: Clo tự do oxy hóa đồng, kẽm, sắt trong ống dẫn nước, van khóa
- Nguy hiểm khi quá liều: Nồng độ > 5 mg/L gây kích ứng mắt, da, đường hô hấp; > 15 mg/L có thể gây buồn nôn, đau bụng

Nhóm đối tượng nhạy cảm:
- Trẻ sơ sinh, phụ nữ mang thai
- Người bệnh thận, gan mãn tính
- Người có hệ miễn dịch suy yếu
- Bệnh nhân hen suyễn, dị ứng hô hấp
—> Có thể bạn quan tâm: [Nước giếng khoan có váng: Nguyên nhân, tác hại và cách xử lý].
2.4. Cách sử dụng Chlorine an toàn cho nước giếng
Việc tính toán liều lượng chính xác và thiết kế hệ thống khử trùng đúng kỹ thuật là yếu tố then chốt để đạt hiệu quả mà không gây độc hại.
|
Công thức tính liều lượng Clo: Lượng Clo cần dùng (mg) = Thể tích nước (L) × Nồng độ mong muốn (mg/L) × 1.2
(Hệ số 1.2 bù trừ cho lượng Clo tiêu hao bởi chất hữu cơ và kim loại)
|
Ví dụ thực tế:
- Giếng khoan 50m³ (50,000 lít) cần khử trùng dư lượng 0.5 mg/L:
- Lượng Clo = 50,000 × 0.5 × 1.2 = 30,000 mg = 30 gram Clo nguyên chất
- Nếu dùng Javel 5% (50,000 mg Clo/lít) thì cần: 30,000 ÷ 50,000 = 0.6 lít Javel
Các bước thực hiện đúng kỹ thuật:
- Tiền xử lý: Lọc bỏ cặn, sắt, mangan trước khi clo hóa (nếu độ đục > 5 NTU)
- Hòa tan: Pha loãng Chlorine trong 5-10 lít nước sạch, khuấy đều
- Bơm định lượng: Sử dụng bơm điện từ (solenoid pump) liều 0.3-0.5 mg/L tự động
- Bình tiếp xúc: Thiết kế thời gian lưu nước tối thiểu 30 phút (CT = 15 mg.phút/L)
- Lọc than hoạt tính: Loại bỏ Clo dư và THMs trước khi đưa vào sử dụng
- Kiểm soát: Đo Clo dư mỗi ngày bằng DPD test kit, duy trì 0.2-0.5 mg/L

—> Có thể bạn quan tâm: [Cặn canxi trong nước: Dấu hiệu, nguyên nhân và 7 cách xử lý hiệu quả].
Lưu ý an toàn khi xử lý hóa chất:
- Đeo găng tay cao su, kính bảo hộ khi pha chế
- Bảo quản Chlorine nơi khô ráo, thoáng mát, tránh ánh sáng
- Không để tiếp xúc với axit, chất hữu cơ dễ cháy
- Giữ xa tầm tay trẻ em, động vật nuôi
III. So sánh hiệu quả diệt khuẩn E.coli giữa UV và Ozone
Hai công nghệ khử trùng vật lý và hóa học tiên tiến này đều mang lại hiệu suất diệt khuẩn cao mà không để lại dư lượng hóa chất độc hại. Tuy nhiên, cơ chế tác động, chi phí đầu tư và điều kiện vận hành của UV và Ozone có sự khác biệt đáng kể.
3.1. Công nghệ UV diệt khuẩn E.coli
Phương pháp chiếu xạ tia cực tím là giải pháp khử trùng hiện đại được ứng dụng phổ biến tại các nước phát triển nhờ tính an toàn cao và không thay đổi thành phần khoáng chất tự nhiên của nước.
Nguyên lý hoạt động:
- Bóng đèn thủy ngân áp suất thấp hoặc đèn amalgam phát ra bức xạ UV-C có bước sóng 254 nanometer.
- Khi photon ánh sáng UV xuyên qua nước và bị hấp thụ bởi phân tử DNA của vi khuẩn, năng lượng photon tạo liên kết cộng hóa trị giữa các base Thymine kế cận (Thymine dimer).
- Cấu trúc DNA bị biến dạng, mất khả năng sao chép và phiên mã, E.coli không thể sinh sản và chết trong vài giây.
Thông số kỹ thuật quan trọng:
- Liều chiếu xạ (UV Dose): 40 mJ/cm² theo tiêu chuẩn NSF/ANSI 55 cho nước uống
- Cường độ UV (UV Intensity): > 16,000 µW/cm² tại đầu ra đèn
- UV Transmittance (UVT): Nước phải có độ truyền UV > 75% (tốt nhất > 85%)
- Thời gian chiếu: 1-3 giây khi nước chảy qua buồng chiếu xạ
Ưu điểm vượt trội:
- Không hóa chất: Giữ nguyên 100% hương vị tự nhiên, không thay đổi pH, độ cứng, khoáng chất
- Tốc độ nhanh: Diệt 99.99% E.coli chỉ trong 1-2 giây, không cần thời gian chờ
- Phổ diệt rộng: Tiêu diệt Giardia, Cryptosporidium (kháng Clo), virus, nấm men
- Thân thiện môi trường: Không tạo sản phẩm phụ, không gây ô nhiễm thứ cấp
- Lắp đặt gọn nhẹ: Thiết bị nhỏ gọn, dễ tích hợp vào hệ thống nước hiện có

—> Có thể bạn quan tâm: [Nồng độ pH của nước giếng khoan: Cách đo và tăng giảm độ pH hiệu quả].
Nhược điểm và hạn chế:
- Yêu cầu nước trong: Độ đục phải < 5 NTU, sắt hòa tan < 0.3 mg/L, mangan < 0.05 mg/L. Nếu nước đục, tia UV bị cản, hiệu quả giảm từ 99.99% xuống còn 90% hoặc thấp hơn
- Bảo dưỡng định kỳ: Vỏ thạch anh bám cặn cần vệ sinh 1-3 tháng/lần. Bóng đèn UV giảm cường độ theo thời gian, cần thay 9-12 tháng/lần
- Không khử trùng dư: Nước sau UV có thể bị tái nhiễm nếu đường ống cũ, bể chứa không vệ sinh
- Phụ thuộc điện: Mất điện thì hệ thống ngừng hoạt động hoàn toàn
Cấu hình hệ thống UV chuẩn: Nước giếng → Lọc cặn PP 5µm → Lọc than hoạt tính → Đèn UV → Bể chứa → Sử dụng
3.2. Công nghệ Ozone diệt khuẩn E.coli
Ozone (O₃) là chất oxy hóa mạnh nhất trong các công nghệ xử lý nước, có khả năng diệt khuẩn, virus và loại bỏ đồng thời nhiều chất ô nhiễm khác.
Nguyên lý tạo và tác dụng:
- Máy phát ozone sử dụng phóng điện corona hoặc tia UV để tách phân tử oxy (O₂) thành nguyên tử oxy tự do (O), sau đó nguyên tử này kết hợp với O₂ tạo thành O₃.
- Khi hòa tan trong nước, ozone phân ly tạo gốc hydroxyl (•OH) và oxy nguyên tử (O) - các chất oxy hóa cực mạnh.
- Chúng tấn công màng phospholipid của tế bào vi khuẩn, phá hủy enzyme cytoplasmic, oxy hóa DNA và RNA. E.coli bị tiêu diệt hoàn toàn chỉ sau vài phút tiếp xúc.
Thông số vận hành:
- Nồng độ ozone: 0.5-2.0 mg/L (ppm) cho khử trùng nước uống
- Thời gian tiếp xúc: 5-10 phút trong bình khuấy trộn
- CT value: 0.5-1.0 mg.phút/L để đạt 99.99% diệt E.coli
- Hệ số chuyển đổi: 1 gram O₃ xử lý được 1,000-2,000 lít nước (tùy chất lượng)
Ưu điểm đặc biệt:
- Sức mạnh oxy hóa: Ozone có tiềm năng oxy hóa 1.52V, mạnh gấp 1.5 lần Chlorine (1.00V), diệt được cả bào tử, nang bào tử kháng Clo
- Đa chức năng: Vừa khử trùng, vừa oxy hóa sắt (Fe²⁺ → Fe³⁺), mangan (Mn²⁺ → MnO₂), loại bỏ màu, mùi H₂S (khí trứng thối)
- Tự phân hủy: O₃ dư tự động chuyển thành O₂ sau 20-30 phút, không để lại chất độc trong nước
- Tăng oxy hòa tan: Cải thiện chất lượng nước, tốt cho cá, tôm trong nuôi trồng thủy sản

—> Có thể bạn quan tâm: [Nồng độ PPM là gì? Bảng chỉ số ppm trong nước tiêu chuẩn].
Nhược điểm và thách thức:
- Chi phí đầu tư cao: Máy phát ozone 5-10 g/h giá từ 20-40 triệu đồng, gấp 3-5 lần UV
- Hệ thống phức tạp: Cần máy phát O₃, bình khuấy trộn Venturi, máy nén khí, bộ phá hủy O₃ dư
- Tiêu thụ điện lớn: Máy ozone 100W-300W chạy liên tục, tốn 72-216 kWh/tháng
- Yêu cầu kỹ thuật: Cần thợ lành nghề lắp đặt, hiệu chuẩn, bảo dưỡng định kỳ
- Khí O₃ độc: Nồng độ > 0.1 ppm trong không khí gây kích ứng đường hô hấp, cần thông gió tốt
Cấu hình hệ thống Ozone: Nước giếng → Lọc cặn → Máy phát O₃ → Bình khuấy Venturi (5-10 phút) → Lọc cát/than → Bể chứa
3.3. Bảng so sánh UV vs Ozone diệt E.coli
|
Tiêu chí so sánh
|
UV (Tia cực tím)
|
Ozone (Khí O₃)
|
|
Hiệu quả diệt E.coli
|
99.99% (4-log)
|
99.99% (4-log), mạnh hơn với bào tử
|
|
Thời gian xử lý
|
1-3 giây (tức thì)
|
5-10 phút (cần tiếp xúc)
|
|
Liều lượng chuẩn
|
40 mJ/cm²
|
0.5-2.0 mg/L × 5-10 phút
|
|
Sử dụng hóa chất
|
Không
|
Không (O₃ tự sản xuất)
|
|
Sản phẩm phụ độc hại
|
Không
|
Không (O₃ → O₂)
|
|
Khử trùng còn dư
|
Không
|
Không (O₃ phân hủy)
|
|
Xử lý sắt, mangan
|
Không
|
Có (oxy hóa Fe, Mn)
|
|
Khử màu, mùi H₂S
|
Không
|
Có (oxy hóa mạnh)
|
|
Yêu cầu độ đục
|
< 5 NTU (nghiêm ngặt)
|
< 20 NTU (chấp nhận cao hơn)
|
|
Chi phí đầu tư
|
8-35 triệu (trung bình)
|
35-65 triệu (cao)
|
|
Chi phí vận hành/tháng
|
180-450 nghìn (thay đèn)
|
540-1,080 nghìn (điện)
|
|
Công suất điện
|
30-120W
|
100-300W
|
|
Tuổi thọ thiết bị
|
Đèn 9-12 tháng, ballast 5-7 năm
|
Máy O₃: 3-5 năm
|
|
Độ phức tạp lắp đặt
|
Đơn giản (tự lắp được)
|
Phức tạp (cần thợ chuyên)
|
|
Phù hợp quy mô
|
Gia đình, trường học, nhà hàng
|
Công nghiệp, khu dân cư, resort
|
|
Ưu tiên khi
|
Nước tương đối sạch, cần giữ khoáng
|
Nước xấu nhiều vấn đề (sắt, mùi, khuẩn)
|
IV. Nước giếng sau khử trùng UV có cần đun sôi hay không?
Câu hỏi này xuất hiện thường xuyên khi các hộ gia đình đầu tư hệ thống đèn UV nhưng vẫn lo ngại về độ an toàn vi sinh. Thực tế, quyết định có cần đun sôi thêm hay không phụ thuộc vào nhiều yếu tố liên quan đến hiệu suất thiết bị và điều kiện hệ thống cấp nước.
4.1. Khả năng diệt khuẩn của đèn UV đạt chuẩn
Đèn UV được sản xuất theo tiêu chuẩn quốc tế NSF/ANSI 55 hoặc NSF/ANSI 244 có khả năng tiêu diệt vi sinh vật ở mức độ rất cao, đáp ứng yêu cầu nước uống trực tiếp.
—> Có thể bạn quan tâm: [Nước giếng khoan bị mặn: Nguyên nhân và cách xử lý].
Hiệu suất theo tiêu chuẩn kỹ thuật:
- Mức diệt E.coli: 99.99% (4-log reduction) khi liều chiếu đạt 40 mJ/cm²
- Các vi sinh vật khác:
- Coliform: 99.999% (5-log)
- Salmonella typhi: 99.99% (4-log)
- Virus Hepatitis A: 99.9% (3-log)
- Nang Giardia: 99.9% (3-log)
- Nang Cryptosporidium: 99.99% (4-log)

Điều kiện để đạt hiệu suất tối đa:
- Công suất đèn phù hợp: Lưu lượng 1,000 lít/giờ cần đèn 30-40W; 2,000 lít/giờ cần 80W; 5,000 lít/giờ cần 120W
- Cường độ UV đủ: Sensor đo cường độ hiển thị > 70% công suất ban đầu (nếu < 70% cần thay đèn)
- Thời gian tiếp xúc: Tốc độ dòng chảy không vượt quá công suất thiết kế (thường 1-3 giây)
- Độ trong của nước: UVT (UV Transmittance) > 75%, tốt nhất > 85%
—> Có thể bạn quan tâm: [Nước phèn ĐBSCL: Giải pháp xử lý chuyên sâu hiệu quả].
Khi các điều kiện trên được đáp ứng, nước ra khỏi đèn UV có chất lượng vi sinh tương đương nước đun sôi, không cần xử lý thêm.
4.2. Trường hợp nước sau UV vẫn cần đun sôi
Dù công nghệ UV hiệu quả, vẫn có những tình huống nước đã qua khử trùng cần đun sôi bổ sung để an toàn tuyệt đối.
Các trường hợp cụ thể:
1. Hệ thống UV đơn lẻ không có tiền xử lý:
- Nước giếng đục > 5 NTU, cặn lơ lửng che chắn tia UV
- Sắt hòa tan > 0.3 mg/L tạo màng rỉ vàng trên vỏ thạch anh
- Mangan > 0.05 mg/L bám đen làm giảm 30-50% cường độ UV
2. Đường ống cũ, xuống cấp:
- Ống sắt rỉ sét, bong tróc tạo khe hở cho vi khuẩn xâm nhập
- Ống PVC cũ nứt, nối không kín bị thấm nước bẩn từ đất
- Mối hàn, chỗ nối van bị lỏng, rò rỉ
3. Bể chứa không vệ sinh:
- Bể inox, bể nhựa không rửa > 6 tháng, tảo phát triển
- Nắp bể hở, côn trùng, chuột, bụi rơi vào
- Biofilm (màng sinh học) hình thành trên thành bể
4. Thiết bị UV hoạt động kém:
- Đèn UV dùng quá 12 tháng, cường độ giảm < 70%
- Vỏ thạch anh bám bẩn dày > 1mm, không vệ sinh định kỳ
- Ballast (nguồn điện) hỏng, điện áp không ổn định
- Lưu lượng nước quá lớn, vượt công suất thiết kế
5. Khu vực nguy cơ cao:
- Mùa dịch, có ca bệnh tiêu chảy trong gia đình
- Trẻ sơ sinh < 6 tháng tuổi, người già, bệnh nhân suy giảm miễn dịch
- Vùng lũ lụt vừa qua, giếng bị ngập nước

—> Có thể bạn quan tâm: [Xử lý nước đục phù sa: Các bước đơn giản tại nhà].
4.3. Điều kiện nước sau UV không cần đun sôi
Để yên tâm sử dụng nước sau UV mà không cần đun sôi, hệ thống phải đáp ứng đầy đủ các tiêu chí kỹ thuật và vận hành sau.
Checklist đảm bảo chất lượng:
Hệ thống lọc tổng hợp: Giếng khoan → Bơm chìm → Lọc cặn PP 5µm → Than hoạt tính 10 inch → Đèn UV → Bể inox 500L → Vòi lấy nước
Yêu cầu thiết bị UV:
- Đèn UV công suất đủ (30-120W tùy lưu lượng)
- Có đồng hồ đếm giờ, cảnh báo khi hết tuổi thọ đèn
- Sensor UV intensity hiển thị cường độ thời gian thực
- Vỏ thạch anh trong sạch, không vết xước, bám cặn
- Thay bóng đèn đúng 9-12 tháng hoặc khi cường độ < 70%
Yêu cầu đường ống và bể chứa:
- Ống inox 304 hoặc PVC cao cấp, mới < 5 năm
- Mối nối kín, không rò rỉ, kiểm tra 6 tháng/lần
- Bể inox có nắp kín, rửa vệ sinh 3-6 tháng/lần
- Van xả đáy để loại bỏ cặn lắng định kỳ
Kiểm soát chất lượng nước:
- Xét nghiệm vi sinh 6 tháng/lần: E.coli = 0, Coliform = 0
- Đo UVT (độ truyền UV) > 85%
- Độ đục < 1 NTU (kiểm tra bằng mắt: nước trong như pha lê)
- Sắt < 0.1 mg/L, Mangan < 0.02 mg/L (không có vết vàng, đen)

—> Có thể bạn quan tâm: [Nước giếng vàng đục sau mưa lũ: 3 Nguyên nhân & Giải pháp].
Cam kết vận hành:
- Vệ sinh vỏ thạch anh 1-3 tháng/lần bằng dung dịch axit citric 5%
- Kiểm tra đèn UV mỗi tuần (quan sát ánh sáng xanh phát ra)
- Thay lõi lọc PP, than hoạt tính 3-6 tháng/lần
- Ghi chép sổ bảo trì như ngày thay đèn, lõi lọc, kết quả xét nghiệm
Khi tất cả điều kiện trên được đáp ứng, nước sau UV có chất lượng vi sinh đạt chuẩn nước uống, an toàn sử dụng trực tiếp mà không cần đun sôi.
V. Chi phí lắp đặt hệ thống khử trùng UV, Ozone và Chlorine
Đánh giá tổng chi phí sở hữu (Total Cost of Ownership) bao gồm cả đầu tư ban đầu và vận hành dài hạn giúp lựa chọn giải pháp tối ưu nhất cho ngân sách.
5.1. Chi phí đầu tư ban đầu
Mức đầu tư thiết bị khử trùng chênh lệch đáng kể giữa các công nghệ, phụ thuộc vào quy mô xử lý và mức độ tự động hóa.
|
Hạng mục
|
Chlorine
|
UV
|
Ozone
|
|
Thiết bị chính
|
|
|
|
|
Bơm định lượng
|
3-8 triệu
|
-
|
-
|
|
Đèn UV gia đình (30-40W)
|
-
|
5-12 triệu
|
-
|
|
Đèn UV công nghiệp (80-120W)
|
-
|
15-30 triệu
|
-
|
|
Máy phát ozone (5-10 g/h)
|
-
|
-
|
20-40 triệu
|
|
Phụ kiện bắt buộc
|
|
|
|
|
Bình chứa hóa chất 20-50L
|
1-2 triệu
|
-
|
-
|
|
Lọc thô tiền xử lý
|
-
|
3-5 triệu
|
5-8 triệu
|
|
Van trộn, phụ kiện Chlorine
|
0.5-1 triệu
|
-
|
-
|
|
Bình khuấy Venturi
|
-
|
-
|
8-12 triệu
|
|
Máy nén khí cho O₃
|
-
|
-
|
5-8 triệu
|
|
Bộ phá hủy O₃ dư
|
-
|
-
|
3-5 triệu
|
|
Lắp đặt và khởi động
|
1-2 triệu
|
1-3 triệu
|
5-10 triệu
|
|
TỔNG ĐẦU TƯ
|
4.5-11 triệu
|
8-35 triệu
|
35-65 triệu
|
|
Mức độ phù hợp
|
Rẻ nhất
|
Trung bình
|
Đắt nhất
|
—> Có thể bạn quan tâm: [Nước giếng có mùi trứng thối (H2S): Nguyên nhân & Cách xử lý].
Ghi chú:
- Giá trên là mức tham khảo tại thời điểm hiện tại, có thể biến động ±10-15% tùy nhà cung cấp.
- Chi phí Ozone chưa bao gồm hệ thống điều khiển PLC tự động (nếu có) thêm 10-15 triệu.
5.2. Chi phí vận hành hàng tháng
Ngoài đầu tư thiết bị, chi phí vận hành dài hạn cũng là yếu tố quyết định tính kinh tế của giải pháp.
|
Khoản mục
|
Chlorine
|
UV
|
Ozone
|
|
Điện năng tiêu thụ
|
|
|
|
|
Công suất thiết bị
|
Bơm 10-20W
|
Đèn 30-120W
|
Máy 100-300W
|
|
Thời gian hoạt động
|
2-4 giờ/ngày
|
16-24 giờ/ngày
|
8-12 giờ/ngày
|
|
Điện năng/tháng
|
1-3 kWh
|
15-90 kWh
|
25-110 kWh
|
|
Chi phí điện (2,500 đ/kWh)
|
2,500-7,500 đ
|
37,500-225,000 đ
|
62,500-275,000 đ
|
|
Vật tư thay thế
|
|
|
|
|
Hóa chất Chlorine
|
100-300 nghìn
|
-
|
-
|
|
Bóng đèn UV (1 năm)
|
-
|
1-3 triệu
|
-
|
|
Vỏ thạch anh (2-3 năm)
|
-
|
0.5-1 triệu
|
-
|
|
Ballast đèn (5-7 năm)
|
-
|
1-2 triệu
|
-
|
|
Cell phát ozone (2-3 năm)
|
-
|
-
|
5-10 triệu
|
|
Vật tư/tháng (tính trung bình)
|
100-300 nghìn
|
80-250 nghìn
|
200-400 nghìn
|
|
Bảo dưỡng, vệ sinh
|
|
|
|
|
Tần suất
|
1 tháng/lần
|
3 tháng/lần
|
1 tháng/lần
|
|
Chi phí (tự làm hoặc thuê)
|
50-100 nghìn
|
0 (tự làm)
|
300-500 nghìn
|
|
Bảo dưỡng/tháng
|
50-100 nghìn
|
0
|
300-500 nghìn
|
|
TỔNG CHI PHÍ/THÁNG
|
150-400 nghìn
|
180-450 nghìn
|
540-1,080 nghìn
|
|
CHI PHÍ/NĂM
|
1.8-4.8 triệu
|
2.1-5.4 triệu
|
6.5-13 triệu
|
—> Có thể bạn quan tâm: [7 Dấu hiệu nước giếng bị nhiễm bẩn (Chi tiết)].
Phân tích chi phí 5 năm:
- Chlorine: Đầu tư 4.5-11 triệu + Vận hành 9-24 triệu = 13.5-35 triệu
- UV: Đầu tư 8-35 triệu + Vận hành 10.5-27 triệu = 18.5-62 triệu
- Ozone: Đầu tư 35-65 triệu + Vận hành 32.5-65 triệu = 67.5-130 triệu
5.3. Lựa chọn theo quy mô và ngân sách
Mỗi công nghệ phù hợp với từng nhóm đối tượng và nhu cầu sử dụng cụ thể.
|
Quy mô sử dụng
|
Lưu lượng/ngày
|
Giải pháp ưu tiên 1
|
Giải pháp ưu tiên 2
|
Lý do lựa chọn
|
|
Hộ gia đình 4-6 người
|
500-1,000 lít
|
Lọc + UV (8-15 triệu)
|
Chlorine đơn giản (4.5-8 triệu)
|
UV an toàn, không hóa chất, phù hợp ăn uống. Chlorine nếu ngân sách hạn chế
|
|
Hộ gia đình lớn 8-10 người
|
1,500-2,000 lít
|
UV 80W (15-20 triệu)
|
Chlorine + Than hoạt tính (8-12 triệu)
|
UV công suất lớn đáp ứng lưu lượng cao
|
|
Nhà hàng, quán ăn
|
2,000-3,000 lít
|
UV công nghiệp (20-30 triệu)
|
Chlorine + Lọc RO (15-25 triệu)
|
Cần nước sạch tuyệt đối cho chế biến thức ăn
|
|
Trường học, văn phòng
|
3,000-5,000 lít
|
UV 120W (25-35 triệu)
|
Ozone nhỏ (35-50 triệu)
|
UV tiết kiệm điện, bảo dưỡng đơn giản
|
|
Trang trại, chăn nuôi
|
5,000-10,000 lít
|
Chlorine quy mô lớn (10-20 triệu)
|
UV công nghiệp kép (40-60 triệu)
|
Chlorine rẻ cho khối lượng lớn, chấp nhận mùi nhẹ
|
|
Nhà máy, khu dân cư
|
>10,000 lít
|
Ozone công nghiệp (60-150 triệu)
|
Chlorine + UV kết hợp (50-100 triệu)
|
Ozone xử lý đa vấn đề (sắt, mùi, khuẩn)
|
|
Resort, khách sạn
|
10,000-20,000 lít
|
Ozone + UV (100-200 triệu)
|
Chlorine + RO công nghiệp (80-150 triệu)
|
Cần chất lượng cao cho du khách
|
—> Có thể bạn quan tâm: [Top 5 nguyên nhân nước giếng nhiễm bẩn (Có giải pháp)].
Khuyến nghị theo ngân sách:
- Dưới 10 triệu: Chlorine + Lọc than hoạt tính (Đơn giản, hiệu quả).
- 10-20 triệu: UV gia đình + Lọc thô (An toàn, không hóa chất).
- 20-40 triệu: UV công nghiệp hoặc Ozone nhỏ (Tùy mục đích).
- Trên 40 triệu: Ozone hoặc Hệ thống tích hợp (Xử lý toàn diện).
VI. Lựa chọn phương pháp xử lý nước giếng nhiễm E.coli phù hợp
Quyết định cuối cùng cần cân nhắc toàn diện các yếu tố: Chất lượng nước đầu vào, ngân sách, mục đích sử dụng, khả năng bảo trì và mức độ an toàn mong muốn.
6.1. Chọn Chlorine khi nào
Phương pháp clo hóa là lựa chọn kinh tế và phổ biến nhất, đặc biệt phù hợp với các trường hợp sau:
Điều kiện ưu tiên Chlorine:
- Ngân sách hạn chế: Tổng đầu tư < 10 triệu đồng, ưu tiên chi phí thấp nhất
- Quy mô lớn: Xử lý > 5,000 lít/ngày, chi phí Chlorine/lít rất thấp
- Cần khử trùng dư: Hệ thống đường ống dài > 50m, cần dư lượng Clo bảo vệ tránh tái nhiễm
- Xử lý toàn hệ thống: Khử trùng giếng, bể chứa, đường ống cùng lúc
- Khu vực khó mua thiết bị: Vùng sâu, vùng xa, không có cửa hàng thiết bị lọc nước chuyên dụng

—> Có thể bạn quan tâm: [Nước giếng có mùi tanh, hôi: Nguyên nhân và cách xử lý hiệu quả].
Điều kiện bắt buộc khi dùng Chlorine:
- Phải kết hợp lọc than hoạt tính sau khử trùng để loại bỏ THMs và mùi Clo dư
- Kiểm soát nồng độ dư lượng 0.2-0.5 mg/L bằng test kit hàng ngày
- Tính toán liều lượng chính xác theo công thức (tránh quá liều gây độc)
- Bảo quản hóa chất đúng cách, tránh ánh sáng, nhiệt độ cao
6.2. Chọn UV khi nào
Công nghệ tia cực tím là giải pháp cân bằng giữa chi phí, hiệu quả và sự an toàn, phù hợp đa số hộ gia đình.
Điều kiện ưu tiên UV:
- Ưu tiên không hóa chất: Muốn giữ 100% hương vị tự nhiên, khoáng chất của nước giếng
- Ngân sách trung bình: Đầu tư 8-35 triệu đồng, chấp nhận được
- Nước tương đối sạch: Độ đục < 5 NTU sau khi lọc thô, sắt < 0.3 mg/L
- Quy mô vừa: 500-5,000 lít/ngày (gia đình, nhà hàng, cơ sở sản xuất nhỏ)
- Có điện ổn định: Không mất điện thường xuyên, điện áp 220V ổn định
Cấu hình hệ thống UV khuyến nghị: Bơm giếng → Bình lọc cặn PP 5µm → Bình lọc than hoạt tính → Đèn UV → Bể inox → Sử dụng

—> Có thể bạn quan tâm: [Lọc nước giếng khoan: Hướng dẫn toàn diện từ A-Z].
Lưu ý quan trọng:
- Bắt buộc phải có lọc thô trước UV (nếu nước đục > 1 NTU)
- Vệ sinh vỏ thạch anh 1-3 tháng/lần tùy chất lượng nước
- Thay bóng đèn đúng 9-12 tháng (không để quá hạn)
- Kiểm tra xét nghiệm vi sinh 6 tháng/lần
6.3. Chọn Ozone khi nào
Ozone là công nghệ cao cấp nhất, chỉ nên đầu tư khi có nhu cầu xử lý chuyên sâu và ngân sách đủ lớn.
Điều kiện ưu tiên Ozone:
- Nước có nhiều vấn đề: Vừa nhiễm E.coli, vừa có sắt (> 0.5 mg/L), mangan (> 0.1 mg/L), mùi H₂S hôi trứng thối
- Ngân sách cao: Đầu tư > 35 triệu đồng, chấp nhận chi phí vận hành 500 nghìn - 1 triệu/tháng
- Quy mô công nghiệp: Nhà máy, khu dân cư, resort, khách sạn, bệnh viện
- Cần xử lý đa chức năng: Vừa khử trùng, vừa oxy hóa kim loại, khử màu, khử mùi cùng lúc
- Có nhân sự kỹ thuật: Thợ lành nghề vận hành, bảo trì thiết bị phức tạp

—> Có thể bạn quan tâm: [8 Cách làm cho nước giếng trong hiệu quả nhất hiện nay].
Khi không nên chọn Ozone:
- Hộ gia đình nhỏ < 6 người (quá đắt, không cần thiết)
- Nước giếng chỉ nhiễm khuẩn đơn thuần (UV rẻ hơn, hiệu quả tương đương)
- Ngân sách hạn chế < 30 triệu
- Không có thợ kỹ thuật bảo dưỡng
6.4. Giải pháp tích hợp tối ưu nhất
Kết hợp nhiều công nghệ theo nguyên tắc "đa rào cản" (multi-barrier) mang lại hiệu quả cao nhất, an toàn tuyệt đối.
Cho hộ gia đình:
|
Bước
|
Công nghệ
|
Mục đích
|
Chi phí
|
|
Bước 1
|
Lọc cặn PP 5 micron
|
Loại bỏ đất sét, cát, rỉ sét
|
0.5-1 triệu
|
|
Bước 2
|
Lọc than hoạt tính
|
Loại bỏ Clo dư, màu, mùi, kim loại
|
1-2 triệu
|
|
Bước 3
|
Đèn UV 30-40W
|
Diệt 99.99% E.coli, vi khuẩn, virus
|
5-12 triệu
|
|
Bước 4
|
Bể chứa inox 500L
|
Lưu trữ nước sạch
|
2-4 triệu
|
|
Tổng đầu tư
|
|
|
8.5-19 triệu
|
|
Vận hành/tháng
|
|
Điện + Thay lõi lọc
|
150-300 nghìn
|
Cho quy mô trung bình (Nhà hàng, trường học): Giếng → Bơm → Lọc cặn đa tầng → Than hoạt tính → UV 80-120W → Chlorine liều thấp 0.2 mg/L → Bể chứa
Ưu điểm: UV diệt khuẩn chính, Chlorine tạo dư lượng bảo vệ nhẹ
Cho quy mô lớn (Công nghiệp, khu dân cư): Giếng → Bơm → Lọc cát đa tầng → Oxy hóa sắt/mangan → Ozone 1.0 mg/L → Lọc than hoạt tính → UV công nghiệp → Chlorine 0.3 mg/L → Bể chứa
|
Thành phần
|
Chức năng
|
Chi phí
|
|
Lọc cát đa tầng
|
Loại cặn, độ đục
|
15-25 triệu
|
|
Bình oxy hóa sắt/mangan
|
Oxy hóa Fe²⁺, Mn²⁺
|
10-15 triệu
|
|
Máy ozone 10 g/h
|
Khử trùng + Oxy hóa
|
30-50 triệu
|
|
Lọc than hoạt tính công nghiệp
|
Loại O₃ dư, màu, mùi
|
8-12 triệu
|
|
UV công nghiệp 120W
|
Bảo hiểm khử trùng
|
25-35 triệu
|
|
Bơm Chlorine
|
Tạo dư lượng 0.3 mg/L
|
5-8 triệu
|
|
TỔNG
|
|
93-145 triệu
|
VII. Kết luận
Vấn đề nước giếng nhiễm E.coli: Sử dụng UV, Ozone hay Chlorine không có câu trả lời duy nhất cho mọi trường hợp. Mỗi công nghệ đều có ưu thế riêng phù hợp với từng điều kiện cụ thể.
.jpg)
Giải pháp khuyến nghị cao nhất cho hộ gia đình là hệ thống tích hợp: Lọc cặn PP → Than hoạt tính → UV → Bể chứa inox với tổng đầu tư 8.5-19 triệu đồng. Cấu hình này loại bỏ cặn bẩn, kim loại, diệt 99.99% E.coli mà không dùng hóa chất, an toàn tuyệt đối cho sức khỏe.

Dù chọn công nghệ nào, yếu tố quan trọng nhất là bảo trì đúng kỳ và kiểm tra chất lượng định kỳ 6 tháng/lần. Hệ thống tốt nhất cũng mất hiệu quả nếu không được vệ sinh, thay linh kiện đúng hạn. Đầu tư vào nước sạch chính là đầu tư cho sức khỏe gia đình, đặc biệt quan trọng với trẻ nhỏ và người cao tuổi.
“Nước giếng nhiễm E.coli: Sử dụng UV, Ozone hay Chlorine” cần được xem xét dựa trên chất lượng nước đầu vào, mục đích sử dụng và điều kiện vận hành thực tế.


Để được tư vấn giải pháp lọc nước giếng khoan, nước nhiễm E.coli phù hợp, đúng kỹ thuật và tối ưu chi phí, vui lòng liên hệ Hotline 091 897 6655 (Miền Nam) hoặc Hotline 093 345 5566 (Miền Bắc) để được VITEKO hỗ trợ trực tiếp.